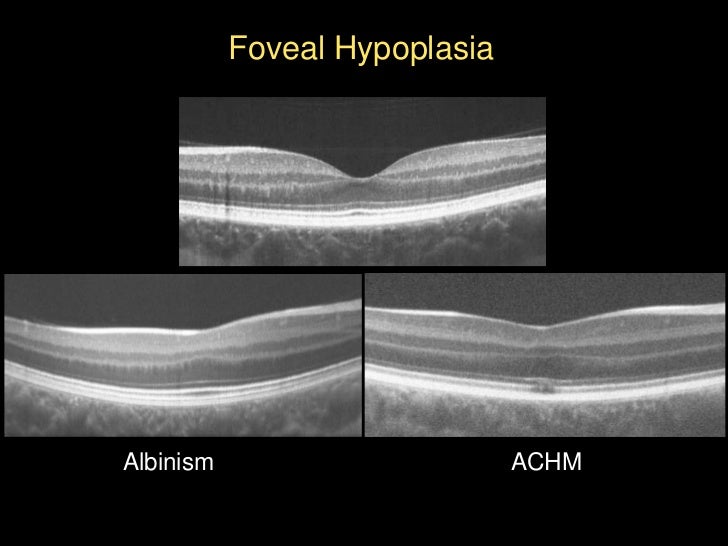

Achromatopsia is an inherited retinal disease that affects the cone cell function. It is a genetic dysfunction of all types of cones1 and is usually an autosomal-recessive disease that affects 1:30,000 to 1:50,000 births. It is characterized by presentation at birth or early infancy with pendular nystagmus, poor visual acuity, lack of color vision, and marked photophobia.

The clinical signs and symptoms of achromatopsia vary. Typical clinical presentation includes photophobia, pendular nystagmus, poor visual acuity, and color vision deficiency, among others. These symptoms usually start at birth or early infancy and their severity varies depending on genetic and phenotypic variability. Other symptoms such as central scotomas or eccentric fixation can also be features of achromatopsia, which can be clinically classified as complete or incomplete depending on the intensity and presence of the different clinical symptoms.
Complete achromatopsia, also known as typical achromatopsia or rod monochromatism, presents during early infancy with photophobia, pendular nystagmus, and poor visual acuity (usually worse than 20/200). The nystagmus and photophobia may become less noticeable over time, but visual acuity remains stable.
In incomplete achromatopsia, also known as atypical achromatopsia, this triad of symptoms may be less intense; in particular, visual acuity can reach up to 20/80.
In these cases, one or more cone types may be partially functioning along with the rods. Fundus examination is usually unremarkable. Evidence of the disease is uncommon and may appear as the narrowing of blood vessels, retinal pigment epithelium disturbances (separated into three categories: presence of retinal pigment epithelium disturbance [50%], no retinal pigment epithelium disturbance [27.5%], and atrophy [22.5%]),5 or alteration of the foveal reflex2 (Figure 1).
The clinical signs and symptoms of achromatopsia vary. Typical clinical presentation includes photophobia, pendular nystagmus, poor visual acuity, and color vision deficiency, among others. These symptoms usually start at birth or early infancy and their severity varies depending on genetic and phenotypic variability. Other symptoms such as central scotomas or eccentric fixation can also be features of achromatopsia, which can be clinically classified as complete or incomplete depending on the intensity and presence of the different clinical symptoms.
Complete achromatopsia, also known as typical achromatopsia or rod monochromatism, presents during early infancy with photophobia, pendular nystagmus, and poor visual acuity (usually worse than 20/200). The nystagmus and photophobia may become less noticeable over time, but visual acuity remains stable.
In incomplete achromatopsia, also known as atypical achromatopsia, this triad of symptoms may be less intense; in particular, visual acuity can reach up to 20/80.
In these cases, one or more cone types may be partially functioning along with the rods. Fundus examination is usually unremarkable. Evidence of the disease is uncommon and may appear as the narrowing of blood vessels, retinal pigment epithelium disturbances (separated into three categories: presence of retinal pigment epithelium disturbance [50%], no retinal pigment epithelium disturbance [27.5%], and atrophy [22.5%]),5 or alteration of the foveal reflex2 (Figure 1).
In both forms of congenital achromatopsia, the signs of achromatopsia may not present until age three to six months of age. The first signs are usually nystagmus, a shaky pendular movement of the eyes and squinting or other signs of aversion to bright light.
The diagnosis of rod monochromatism and blue cone monochromatism is based on medical history, color vision testing, electroretinogram testing, and a lack of significant retinal signs in young patients. Mild pigmentary retinal changes or “bulls eye” pigmentation may occur in older patients.
In the past, early diagnosis was complicated since infants could not perform the color vision testing to confirm the diagnosis. Today, genetic testing may aid in diagnosis of some of the most common forms of rod monochromatism.
Medical History
A history of aversion to light, squinting, nystagmus, decreased vision and profound color vision loss together may suggest a diagnosis of a cone dysfunction syndrome, which could include achromatopsia.
Age of Onset
An onset from near birth helps supports a diagnosis of achromatopsia versus progressive cone dystrophies, which may have a later onset. In infants, the squinting may not be present until three to six months of age.
Family History
Rod monochromatism is an autosomal recessive condition. Thus it requires both parents to be carriers of the mutation. This means that there is usually no history of rod monochromatism in parents or grandparents. There may be cases in fellow siblings (brothers and/or sisters) as each child of a set of carrier parents has a 25% chance of having the condition.
Blue cone monochromatism is an X-linked recessive. It is also known a X-linked recessive monochromatism. It is inherited from the mother primarily to males. It is possible to occur in females, but may be as rare as 1 in 10 billion births. A pattern of occurrence of the problem in a grandfather or male cousins on the mother’s side could help support the diagnosis.
Visual Acuity
Vision loss in rod monochromatism is usually in a range of 20/120 to 20/200. Incomplete cases may be slightly better. Blue cone monochromatism frequently presents with visual acuities of 20/60 to 20/120. Visual acuity can fluctuate greatly dependent on lighting levels in testing and the effects of increases in nystagmus that may occur when one eye is covered.
Refractive Error
There is a significant incidence of hyperopia or farsightedness in rod monochromats. This can make eyewear slightly thicker.However, there is a wide range of refractive error including myopia and astigmatism. Many blue cone monochromats show significant amounts of myopia.
Progression of Vision Loss
Generally achromatopsia does not show major progression of vision loss. It is usually stable with rare exceptions. If the vision loss shows significant progression over time, the patient may have a progressive cone dystrophy.
The Flynn Phenomenon
After exposure to bright light for several minutes, if the patient is placed in the dark, a paradoxical pupilliary constriction may occur in many rod monochromats. The pupil may constrict rather than dilate as expected. This also occurs in a number of other pediatric conditions thus it is of limited help in diagnosing achromatopsia. It has been reported more commonly in rod monochromats, but studies now show it can also occur in blue cone monochromats.
Nystagmus
The nystagmus is usually pendular in the horizontal plane. However, other forms and directions of the nystagmus have been reported. Nystagmus may vary on stress and direction of gaze. It may increase when one eye is covered as in visual acuity testing.Nystagmus often decreases in the first decade of life.
Molecular Genetic Testing
Rod monochromatism genetic mutations which are now referred to as “variants” have been identified in genes, CNGA3, CNGB3, and GNAT2 that account for about 77% cases of rod monochromatism. Blue cone monochromatism has been linked to two mutations in on the X-chromosome at OPN1W and OPN1MW.
In the United States, the John and Marcia Carver Laboratory at the University of Iowa provides molecular genetic testing for a range of eye conditions. It is a not-for-profit laboratory and thus costs of genetic testing is not expensive.
The John and Marcia Carver Laboratory currently provide testing for the two most common mutations associated with rod monochromatism CNGA3 and CNGB3. These two variants account for 75% of the cases of rod monochromatism. Counseling by the doctor or other designated health care provider is required. They will issue a report to the doctor that will indicate the likelihood of the gene causing the condition.
They use a scoring system called the Estimate of Pathogenic Probability or EPP. An EPP of 0 would indicate the variant is a non disease causing polymorphism while a score of 3 would indicate that the variant is highly likely to be a high penetrance disease causing variant.
Optical Coherence Tomography: The Photoreceptor Integrity Line
Optical Coherence Tomography or OCT, is a new method of scanning the fine structures of the central retina, whichcan help confirm dysfunction of cones in the center of the retina. The signal from the outer and inner segments of the cones and rods in the retina can be imaged by OCT. Only cones are normally present in the fovea, the very center of the retina. Thus, we can look at this region to see if there is a loss of signal helping to help confirm a cone dysfunction.
This line is created by the junction of inner/outer segment of the rods and cones and is now being designated the photoreceptor integrity line. It is very helpful in diagnosing cone dysfunction syndromes.

Unfortunately, this test cannot be done on very young children and infants owing to the need to fixate in the target in the scanner.
Below, a technician demonstrates the results of a Cirrus Optical Coherence Tomography scan on a patient with achromatopsia. The examples below show the impairment in the photoreceptor integrity line as it passes through the fovea where only cones would be present. In some cases, a serous detachment of the photoreceptor layer may be defined.

Electroretinogram
The ERG (electroretinogram) tests the photopic bright light response that would have been produced by the cones, which are missing or profoundly reduced, but the scotopic low light response dependent on the rods is normal or only minimally reduced or delayed.

The ERG also has value in differentiating rod monochromatism, which demonstrate delayed scotopic ERG and loss of 30 Hz cone ERG from progressive cone dystrophies, which show normal scotopic ERG, and a partially maintained cone ERG.
This is a difficult test for infants and small children to perform. Hopefully, in the future, genetic testing will lesson the need for this test.
Color Vision Testing
The D-15 and Munsell 100 Hue tests require a patient to align the colored disks into a continuous progression. They can be used to demonstrate the severe impairment and can sometimes provide diagnostic help in differentiating rod monochromats from blue cone monochromats.


Rod monochromats may demonstratean achromatic axis on on both the saturated and desaturated versions of the D-15. This is an axis in which the color disks are arranged to match the way rods would perceive their brightness rather than by color.
The D-15 test result to the left shows an achromat axis common to Rod Monochromats.
There is no specific axis of color confusion on tests like the Munsell 100-Hue test.

It may be possible to differentiate some blue cone monochromats from rod monochromats by the protan-like arrangement of the color disks on the D-15 or FM 100 Hue Test. However, not all blue cone monochromats behave in this manner. Some may appear more like the rod monochromat do on these tests.
The D-15 test results to the right demonstrates the typical protan-like results demonstrated in many blue cone monochromats.
Two tests useful in achromatopsia testing, the Sloan Achromatopsia test and the Berson test, are now very difficult to obtain. The Berson Test can help differentiate blue cone monochromatism from rod monochromatism, but cannot differentiate progressive cone dystrophies from the blue cone monochromat.
Many other color vision tests, as demonstrated below, may be used to initially screen color vision and demonstrate the severity of the color vision loss, but may not provide help in differentiating between each condition. The HRR test below can be helpful in some incomplete forms of achromatopsia.

Retinal Examination
Most achromats have normal retinal findings on ophthalmoscopy. Some may show a reduced or absent foveal reflex, slight attenuation of retinal vessels and pigmentary changes in the macula. The “normal” retinal picture and the rod monochromat retinal picture below look identical. We cannot diagnose achromatopsia from the retinal appearance alone but a lack of visible abnormalities can support the diagnosis in the presence of the symptoms of light aversion, decreased vision, profound color vision loss and nystagmus.


Older patients may sometimes demonstrate “bull eye” pigmentary changes around the macula.
Visual Fields Testing
Visual fields testing may demonstrate small central scotomas, areas of vision loss corresponding to the central retina area. See the small black squares in the center of the cross. These are the only areas that the achromat missed.

It has been reported that yellow-blue perimetry (Sita-swap) may be helpful in differentiating blue cone monochromats versus rod monochromats.
Dark Adaptation Testing
There is an absence of the Kohlrausch Kink, which represents the cone-rod break in dark adaptation.
Measurements of Spectral Sensitivity
In rod monochromats, there may be a shift of the peak spectral sensitivity from the expected 555 nm, which is the peak wavelength sensitivity of cones to 507 nm, the peak wavelength of rods.
read more @ http://www.achromatopsia.info
